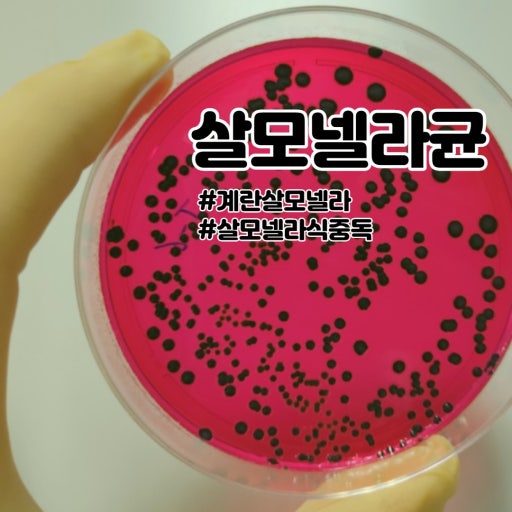

<완전식품 달걀 매일 날달걀로 먹으면 탈모온다>
완전식품 ‘달걀’을 건강하게 먹는 법

달걀은 단백질, 비타민, 미네랄이 풍부해 완전식품으로 불리지만,
어떻게 먹느냐에 따라 우리 몸에 주는 영향이 달라집니다.
특히 날달걀을 그대로 먹는 것은 주의가 필요합니다.

1. 날달걀 섭취 시 주의해야 할 점
날달걀의 흰자에는 ‘아비딘’이라는 성분이 들어 있습니다.
이 성분은 비오틴(비타민 B7)과 결합해 몸이 비오틴을 흡수하지 못하게 막습니다.
비오틴은 머리카락 생성과 피부 건강에 필요한 영양소입니다.
날달걀을 자주 먹으면 비오틴 부족으로 탈모나 피부 트러블이 생길 수 있습니다.
달걀을 익히면 아비딘이 열에 의해 파괴되므로 비오틴 흡수 방해 없이 안심하고 먹을 수 있습니다.

2. 단백질 흡수율 차이
달걀은 고품질 단백질의 대표 식품이지만, 익힌 정도에 따라 흡수율에 큰 차이가 있습니다.
조리 상태단백질 흡수율
| 완숙 달걀 | 약 91% |
| 날달걀 | 약 52% |
단백질은 근육뿐 아니라, 모발과 손톱 생성에도 필요합니다.
완전히 익힌 달걀을 먹는 것이 단백질을 더 많이, 효율적으로 섭취하는 방법입니다.

3. 식중독 예방 수칙
날달걀 또는 껍데기에 묻은 살모넬라균은 식중독을 유발할 수 있습니다.
특히 어린이, 임산부, 면역력이 약한 사람은 더욱 조심해야 합니다.
예방을 위한 팁:
- 달걀을 만진 뒤에는 손을 비누로 씻기
- 껍데기를 깨기 전 깨끗이 씻기
- 가급적 익혀서 섭취하기 (삶기, 굽기 등)
- 달걀은 냉장 보관하며 유통기한 확인하기
요약하면
날달걀은 비오틴 흡수를 방해하고, 단백질 흡수율도 낮으며 식중독 위험이 있습니다.
익힌 달걀은 영양소 흡수율도 높고, 안전합니다.
간편하고 영양가 높은 완숙 달걀로 건강을 챙기는 것이 좋습니다.